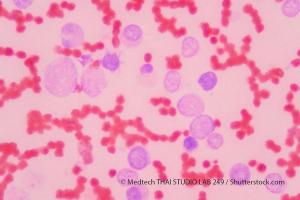

The US Food and Drug Administration recently approved alpelisib plus fulvestrant for the treatment of metastatic or otherwise advanced breast cancer.

The US Food and Drug Administration recently approved alpelisib plus fulvestrant for the treatment of metastatic or otherwise advanced breast cancer.

Highlights of breast cancer advances at the ESMO Congress.

Researchers look at cost estimates stratified by stage, histology, and level of treatment.

This year has seen many advances in immunotherapy. Here is a look at some of the most significant research.

Researchers explore the predictive capability of EVI1 expression.

Researchers report on the BRIGHT AML 1019 Phase III trial.

A review of recent advances in the noninvasive imaging of immunotherapeutic targets.

Researchers look at how mutation status can influence responses to targeted therapy in thyroid cancer.

Genetic profiles of thyroid cancer shed light on molecular mechanisms.

Investigators assessed effects of TIB on cell number, migration, invasion, estrogen, and progesterone receptor activity and content.

Several promising drugs for the treatment of lung cancer have been garnering attention over recent years. These new treatments have been highlighted at conferences and are sure to impact the standard of care.

In this study, FLT3-IRAK1/4 inhibitor (NCGC1481) removed adaptively resistant FLT3-mutant AML cells.

Prognostic signature associated with AML relapse risk potential harbors gene subsets that apply to only certain patient subgroups.

Age disparities in oncology trials are continuing, despite opposition to this issue.

In this phase III trial, investigators assessed the clinical efficacy and safety of durvalumab with or without tremelimumab with etoposide and carboplatin or cisplatin chemotherapy followed by durvalumab with or without tremelimumab maintenance therapy compared with EP alone as first-line treatment in extensive-stage small-cell lung cancer.

Video-assisted thoracic surgery (VATS) results in fewer in-hospital complications and a shorter length of stay compared with open surgery in patients with early-stage lung cancer.

In a phase I trial, researchers demonstrated that KRAS inhibitor AMG 510 demonstrated safety and antitumor activity in advanced NSCLC patients.

Combination immunotherapy with nivolumab plus ipilimumab was examined as a first-line therapy for patients with advanced non–small-cell lung cancer. Results were presented at the International Associate for the Study of Lung Cancer 2019 World Conference on Lung Cancer.

Data presented at the International Association for the Study of Lung Cancer 2019 World Conference on Lung Cancer suggested tumor mutational burden may not be associated with the efficacy of pembrolizumab plus chemotherapy or placebo plus chemotherapy.

Little research has been done on these complications commonly found in lung cancer.

A new orally active inverse agonist of estrogen-related receptor gamma (ERRү) called DN200434 shows promise with regard to the diagnosis and treatment of anaplastic thyroid cancer.

In late 2015, the American Thyroid Association (ATA) changed guideline recommendations trying to rein in overly aggressive treatment of thyroid cancers that are low risk, offering the choice of hemithyroidectomy as an alternative to total thyroidectomy in these patients. In participating hospitals, the rates of hemithyroidectomy went up.

Researchers focused on a subset of patients with high tumor mutational burden using a 20-mutation-per-megabase threshold and found significant improvement in progression-free survival and overall survival.

ESR2 rs3020450 polymorphism was linked to ovarian cancer risk at a population level, while high ESR2 expression levels were associated with long survival in ovarian cancer patients.

Findings from the upcoming International Association for the Study of Lung Cancer 2019 World Conference on Lung Cancer show camrelizumab and chemotherapy showed survival benefits for patients with metastatic or otherwise advanced non-squamous non–small-cell lung cancer.

Researchers identified a highly recurrent, disease-specific PP2A PPP2R1A mutation as a driver of endometrial carcinoma and as a target for new drugs.

Researchers examined several studies of patients with Graves' Disease to see the prevalence of thyroid cancer in this population.

Prostate cancer is the most frequent cancer found in American men, and the second leading cause of cancer death in this population. Currently, scores of reputable clinical trials are underway and recruiting patients.

Atezolizumab is an immune-checkpoint inhibitor, which has been approved by the US Food and Drug Administration (FDA) in various combinations for a number of cancer types in recent years.

The US Food and Drug Administration recently approved gilteritinib (Xospata), in addition to final trial data from the phase 3 ADMIRAL trial, making it the new standard of care for acute myeloid leukemia.

September 10th 2018

September 13th 2018

September 13th 2018

September 17th 2018
September 19th 2018